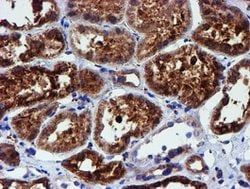
Img

50-166-2448
USP10 Mouse anti-Canine, Human, Mouse, Rat, Clone: OTI2E1, lyophilized, TrueMAB™
Manufacturer: OriGene
Select a Size
| Pack Size | SKU | Availability | Price |
|---|---|---|---|
| Each of 1 | 50-166-2448-Each-of-1 | In Stock | ₹ 60,342.00 |
50-166-2448 - Each of 1
In Stock
Quantity
1
Base Price: ₹ 60,342.00
GST (18%): ₹ 10,861.56
Total Price: ₹ 71,203.56
Antigen
USP10
Classification
Monoclonal
Conjugate
Unconjugated
Gene
USP10
Gene Alias
UBPO
Host Species
Mouse
Purification Method
Affinity Chromatography
Regulatory Status
RUO
Gene ID (Entrez)
22224, 307905, 479625, 9100
Content And Storage
-20° C, Avoid Freeze/Thaw Cycles
Form
Lyophilized
Applications
Flow Cytometry, Immunocytochemistry, Immunofluorescence, Immunohistochemistry (Paraffin), Western Blot
Clone
OTI2E1
Formulation
PBS with 8% trehalose and no preservative; pH 7.3
Gene Accession No.
P52479, Q14694, Q3KR59
Gene Symbols
Usp10
Immunogen
Full length human recombit protein of human USP10 produced in HEK293T cell.
Quantity
100 μg
Primary or Secondary
Primary
Target Species
Canine, Human, Mouse, Rat
Product Type
Antibody
Isotype
IgG1
Description
- Reconstitute with PBS (pH 7.3) and recommend to perform another round of desalting process using Product No
- 7KMWCO Ubiquitin is a highly conserved protein that is covalently linked to other proteins to regulate their function and degradation
- This gene encodes a member of the ubiquitin-specific protease family of cysteine proteases
- The enzyme specifically cleaves ubiquitin from ubiquitin-conjugated protein substrates
- The protein is found in the nucleus and cytoplasm
- It functions as a co-factor of the DNA-bound androgen receptor complex, and is inhibited by a protein in the Ras-GTPase pathway
- The human genome contains several pseudogenes similar to this gene.
Compare Similar Items
Show Difference
Antigen: USP10
Classification: Monoclonal
Conjugate: Unconjugated
Gene: USP10
Gene Alias: UBPO
Host Species: Mouse
Purification Method: Affinity Chromatography
Regulatory Status: RUO
Gene ID (Entrez): 22224, 307905, 479625, 9100
Content And Storage: -20° C, Avoid Freeze/Thaw Cycles
Form: Lyophilized
Applications: Flow Cytometry, Immunocytochemistry, Immunofluorescence, Immunohistochemistry (Paraffin), Western Blot
Clone: OTI2E1
Formulation: PBS with 8% trehalose and no preservative; pH 7.3
Gene Accession No.: P52479, Q14694, Q3KR59
Gene Symbols: Usp10
Immunogen: Full length human recombit protein of human USP10 produced in HEK293T cell.
Quantity: 100 μg
Primary or Secondary: Primary
Target Species: Canine, Human, Mouse, Rat
Product Type: Antibody
Isotype: IgG1
Antigen:
USP10
Classification:
Monoclonal
Conjugate:
Unconjugated
Gene:
USP10
Gene Alias:
UBPO
Host Species:
Mouse
Purification Method:
Affinity Chromatography
Regulatory Status:
RUO
Gene ID (Entrez):
22224, 307905, 479625, 9100
Content And Storage:
-20° C, Avoid Freeze/Thaw Cycles
Form:
Lyophilized
Applications:
Flow Cytometry, Immunocytochemistry, Immunofluorescence, Immunohistochemistry (Paraffin), Western Blot
Clone:
OTI2E1
Formulation:
PBS with 8% trehalose and no preservative; pH 7.3
Gene Accession No.:
P52479, Q14694, Q3KR59
Gene Symbols:
Usp10
Immunogen:
Full length human recombit protein of human USP10 produced in HEK293T cell.
Quantity:
100 μg
Primary or Secondary:
Primary
Target Species:
Canine, Human, Mouse, Rat
Product Type:
Antibody
Isotype:
IgG1
Antigen: LPL
Classification: Monoclonal
Conjugate: Unconjugated
Gene: LPL
Gene Alias: HDLCQ11, LIPD
Host Species: Mouse
Purification Method: Affinity Chromatography
Regulatory Status: RUO
Gene ID (Entrez): 4023
Content And Storage: -20° C, Avoid Freeze/Thaw Cycles
Form: Lyophilized
Applications: Immunocytochemistry, Immunofluorescence, Immunohistochemistry (Paraffin), Western Blot
Clone: OTI4G7
Formulation: PBS with 8% trehalose and no preservative; pH 7.3
Gene Accession No.: P06858
Gene Symbols: LPL
Immunogen: Human recombit protein fragment corresponding to amino acids 28-475 of human LPL produced in HEK293T cell.
Quantity: 100 μg
Primary or Secondary: Primary
Target Species: Human
Product Type: Antibody
Isotype: IgG1
Antigen:
LPL
Classification:
Monoclonal
Conjugate:
Unconjugated
Gene:
LPL
Gene Alias:
HDLCQ11, LIPD
Host Species:
Mouse
Purification Method:
Affinity Chromatography
Regulatory Status:
RUO
Gene ID (Entrez):
4023
Content And Storage:
-20° C, Avoid Freeze/Thaw Cycles
Form:
Lyophilized
Applications:
Immunocytochemistry, Immunofluorescence, Immunohistochemistry (Paraffin), Western Blot
Clone:
OTI4G7
Formulation:
PBS with 8% trehalose and no preservative; pH 7.3
Gene Accession No.:
P06858
Gene Symbols:
LPL
Immunogen:
Human recombit protein fragment corresponding to amino acids 28-475 of human LPL produced in HEK293T cell.
Quantity:
100 μg
Primary or Secondary:
Primary
Target Species:
Human
Product Type:
Antibody
Isotype:
IgG1
Antigen: __
Classification: __
Conjugate: __
Gene: __
Gene Alias: __
Host Species: __
Purification Method: __
Regulatory Status: __
Gene ID (Entrez): __
Content And Storage: __
Form: __
Applications: __
Clone: __
Formulation: __
Gene Accession No.: __
Gene Symbols: __
Immunogen: __
Quantity: __
Primary or Secondary: __
Target Species: __
Product Type: __
Isotype: __
Antigen:
__
Classification:
__
Conjugate:
__
Gene:
__
Gene Alias:
__
Host Species:
__
Purification Method:
__
Regulatory Status:
__
Gene ID (Entrez):
__
Content And Storage:
__
Form:
__
Applications:
__
Clone:
__
Formulation:
__
Gene Accession No.:
__
Gene Symbols:
__
Immunogen:
__
Quantity:
__
Primary or Secondary:
__
Target Species:
__
Product Type:
__
Isotype:
__
Antigen: PDIA4
Classification: Monoclonal
Conjugate: Unconjugated
Gene: PDIA4
Gene Alias: ERP70, ERP72, ERp-72
Host Species: Mouse
Purification Method: Affinity Chromatography
Regulatory Status: RUO
Gene ID (Entrez): 482715, 9601
Content And Storage: -20° C, Avoid Freeze/Thaw Cycles
Form: Lyophilized
Applications: Immunohistochemistry (Paraffin), Western Blot
Clone: OTI2C11
Formulation: PBS with 8% trehalose and no preservative; pH 7.3
Gene Accession No.: P13667
Gene Symbols: PDIA4
Immunogen: Full length human recombit protein of human PDIA4 produced in HEK293T cell.
Quantity: 100 μg
Primary or Secondary: Primary
Target Species: Canine, Human
Product Type: Antibody
Isotype: IgG2b
Antigen:
PDIA4
Classification:
Monoclonal
Conjugate:
Unconjugated
Gene:
PDIA4
Gene Alias:
ERP70, ERP72, ERp-72
Host Species:
Mouse
Purification Method:
Affinity Chromatography
Regulatory Status:
RUO
Gene ID (Entrez):
482715, 9601
Content And Storage:
-20° C, Avoid Freeze/Thaw Cycles
Form:
Lyophilized
Applications:
Immunohistochemistry (Paraffin), Western Blot
Clone:
OTI2C11
Formulation:
PBS with 8% trehalose and no preservative; pH 7.3
Gene Accession No.:
P13667
Gene Symbols:
PDIA4
Immunogen:
Full length human recombit protein of human PDIA4 produced in HEK293T cell.
Quantity:
100 μg
Primary or Secondary:
Primary
Target Species:
Canine, Human
Product Type:
Antibody
Isotype:
IgG2b